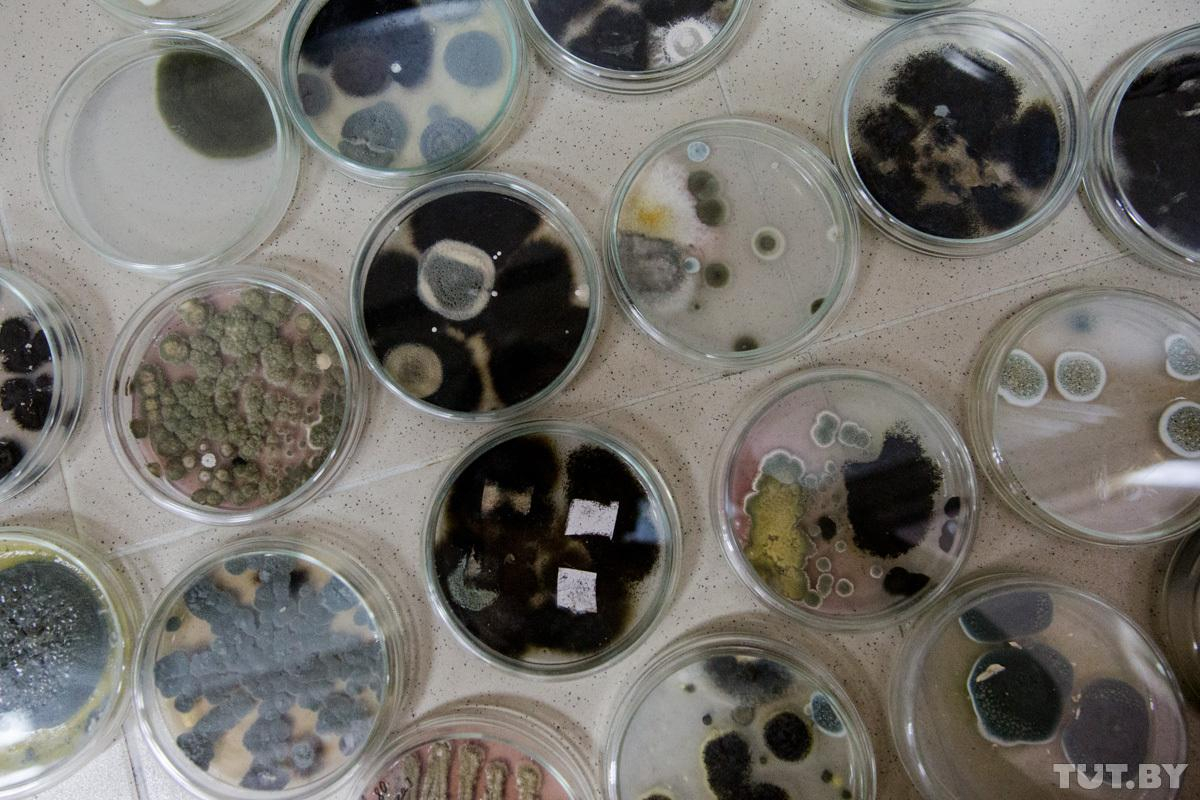
Аллергия на плесень: симптомы и профилактика

Кроме того, плесневые грибы активно размножаются в мертвых растениях – именно поэтому у людей с аллергией на плесень возможно усиление симптомов в начале осени, когда накапливаются опавшие листья, и в начале весны, когда из-под талого снега высвобождаются споры, рассказала аллерголог Ольга Жоголева.
Читайте также: Можно ли есть "здоровые" части заплесневелых продуктов
Симптомы аллергии на плесень
Симптомы аллергии на плесень чаще несут дыхательные проявления:
- насморк с обильным водянистыми выделениями;
- зуд в полости носа,
- чихание;
- заложенность носа,
- зуд и покраснение глаз
- слезотечение
- кашель,
- затруднение дыхания;
- свистящее дыхание.
Плесень может вызвать тяжелую аллергию
Плесень и астма
При наличии очагов плесени дома астматика необходимо тщательно от нее избавляться, плесень может вызвать обострение или осложнять проявления (впрочем, эта рекомендация подходит даже для здоровых людей). Виновником 80% аллергии на плесень является гриб Alternaria alternata. Другим частым аллергеном является Cladosporium.
Факторы риска возникновения аллергии
- члены вашей семьи – аллергики;
- проживание в помещении с высокой влажностью;
- проживание в доме, который раньше затапливало;
- проживание в доме с плохой вентиляцией;
- работа в условиях контакта с плесенью (например, выпечка, производство вина,
- реставрационные работы, починка мебели, работа на ферме).
Другие новости, касающиеся лечения, медицины, питания, здорового образа жизни и многое другое – читайте в разделе Здоровье. ⠀